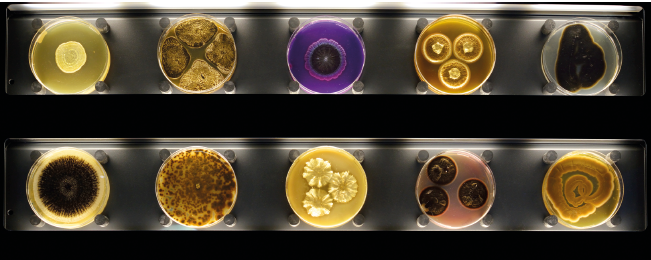
Imagem: Fotografia. Placas divididas em três fileiras com lâminas de análise circulares com bactérias em tons diversos de amarelo, marrom e roxo. Fim da imagem.

72
UNIDADE 3. Vida microscópica

73
Boxe complementar:
Primeiros contatos
- Você reconhece os seres vivos que aparecem na imagem? Quais?
Fim do complemento.
74
DESAFIO À VISTA!
Capítulo 9
Neste capítulo, você vai identificar alguns microrganismos e seus papéis no local em que são encontrados.
Qual é a importância dos diversos microrganismos que estão ao nosso redor?
Será que podemos encontrar microrganismos em todos os lugares? Vamos fazer uma Atividade prática para investigar?
Atividade prática
Onde podemos encontrar microrganismos?

Organizem-se em grupos para a realização da atividade.
- Converse com um
colega
e indiquem os locais onde podem ser encontrados microrganismos e os locais onde, na opinião de vocês, eles não podem ser encontrados. Escrevam no
caderno
suas hipóteses.
Do que vocês vão precisar
- hastes flexíveis com pontas de algodão
- gelatina
- filme plástico
- potes plásticos
- etiquetas adesivas
Como fazer
- Solicitem a um adulto que prepare a gelatina, coloquem-na em alguns potes e deixem-na endurecer na geladeira.
- Cubram um dos potes com filme plástico e identifiquem-no como “controle”. Ele servirá de referência para o experimento.

75
- Umedeçam o algodão das hastes flexíveis e esfreguem-no em superfícies de objetos e locais que queiram testar. Usem uma haste para cada teste.
- Observação: ATENÇÃO: Não comam a gelatina! Fim da observação
- Cuidadosamente, passem o algodão pela superfície da gelatina dos outros potes. Cada pote deve corresponder a um objeto ou local testado.
- Cubram os potes de gelatina com filme plástico.
- Identifiquem cada pote com o nome do objeto ou do local que está sendo testado.
- Deixem os potes reservados por três dias fora da geladeira.
- Observem os potes diariamente.

- Desenhe e descreva o que vocês observaram na gelatina em cada um dos potes ao final do terceiro dia de observação.
- A gelatina do pote controle ficou diferente da gelatina dos outros potes? Se sim, o que você acha que causou essa diferença?
- Tente explicar por que os microrganismos não são visíveis nos objetos e nos locais onde foram coletados, mas podem ser vistos nos potes em que foram realizados os testes?
- Com base no resultado desta atividade, o que você pode dizer sobre a presença de microrganismos no ambiente ao seu redor? As hipóteses que vocês formularam no início da atividade foram confirmadas?
- Escreva um argumento para explicar suas conclusões e compartilhe com seus familiares. Pergunte a eles se já notaram a presença de microrganismos em sua moradia.
76
Microrganismos
Os microrganismos podem estar em todos os lugares. Podem ser encontrados no ar, no solo, na água e no corpo dos seres vivos. Alguns deles sobrevivem em altas temperaturas, e outros, em temperaturas muito baixas. Podem ser usados na produção de alguns alimentos, como pães, iogurtes e queijos, e em medicamentos e combustíveis.
A identificação de microrganismos está relacionada com o desenvolvimento do microscópio. Esse equipamento contém lentes que possibilitam a observação ampliada da imagem dos microrganismos.


- Com um colega, pesquise a história do desenvolvimento do microscópio, incluindo imagens relacionadas ao assunto. Além de registrar no caderno o resultado da pesquisa, utilize, se possível, um meio digital para comunicar suas descobertas.
77
Bactérias
As bactérias são seres microscópicos que têm apenas uma célula . Podem viver sozinhas ou em grupos, formando colônias. Para elas se alimentarem, podem, entre outras ações, decompor a matéria orgânica. Por isso, como já vimos, as bactérias são seres decompositores.

LEGENDA: Essas bactérias vivem no corpo humano de forma inofensiva . (Imagem obtida de microscópio eletrônico, colorizada artificialmente e ampliada cerca de 6 mil vezes.) FIM DA LEGENDA.

LEGENDA: Não é possível enxergar a olho nu as bactérias que participam da decomposição de galhos, frutos e folhas caídos no solo. FIM DA LEGENDA.

LEGENDA: As colônias de bactérias que causam a tuberculose ( Mycobacterium tuberculosis) podem ser vistas a olho nu. FIM DA LEGENDA.
Bactérias presentes no ar ou nos próprios alimentos podem deteriorá-los, deixando-os impróprios para consumo. Um dos processos responsáveis pela deterioração de alimentos é a fermentação. Nesse processo, as bactérias utilizam o alimento para obter energia.
Alguns tipos de fermentação são usados pelos seres humanos, como a fermentação do leite feita por bactérias, que resulta em iogurtes. Essas bactérias mudam a textura e o sabor do leite sem estragar o alimento, por isso podemos consumi-lo.
Outro exemplo da ação das bactérias está dentro da nossa boca. A cárie é provocada pela ação de bactérias que atacam os dentes. Quando encontram restos de alimentos, as bactérias presentes na boca utilizam esse alimento e liberam, nesse processo, uma substância que corrói os dentes.

LEGENDA: Representação esquemática de cárie se formando no dente. (Imagem sem escala; cores fantasia.) FIM DA LEGENDA.
- Que cuidados devemos ter para evitar cáries?
78
Protozoários
Os protozoários também são seres muito pequenos e constituídos de uma única célula. Habitam principalmente ambientes como rios, lagos e mares.
Alguns deles podem causar doenças, como a amebíase, doença provocada por protozoários que se alojam no aparelho digestório dos seres humanos. Se fezes de pessoas contaminadas atingirem a água e os alimentos, a doença pode ser transmitida a outras pessoas que os consumirem.
- A malária é uma doença provocada por protozoários. Observe a imagem e pesquise informações sobre os sintomas da malária e sobre como evitá-la.

LEGENDA: Representação esquemática da transmissão da malária. (Imagem sem escala; cores fantasia.) FIM DA LEGENDA.
Fonte: SIQUEIRA, A. et al. Malária na atenção básica. Belo Horizonte: Nescon/UFMG, 2018. Disponível em: http://fdnc.io/fee. Acesso em: 7 jun. 2021.
Fungos
Alguns fungos são visíveis a olho nu, como os cogumelos e as orelhas-de-pau, mas muitas espécies são microscópicas e podem estar em quase todos os ambientes. Esses organismos são chamados de decompositores. Alguns fungos podem ser utilizados na alimentação, enquanto outros são venenosos.
Há também os fungos parasitas, que podem causar doenças como as micoses, um tipo de infecção que atinge pele, unhas e couro cabeludo. Os fungos precisam de ambientes úmidos para crescer e se desenvolver.

LEGENDA: Fungos comestíveis (Lyophyllum shimeji, altura aproximada: 8 cm). FIM DA LEGENDA.
- Durante o verão, principalmente nas pessoas que frequentam praia e piscina, é comum o aparecimento de micoses na pele. Considerando que os fungos se desenvolvem em lugares úmidos, qual é a melhor maneira de evitar micoses?
79
Boxe complementar:
Quero saber!
Como podemos tratar doenças causadas por bactérias?
Imagine uma descoberta que possibilitasse a cura de várias doenças fatais e que permitisse salvar a vida de milhões de pessoas de uma só vez. Pensou? Pois essa descoberta já aconteceu! […]
Alexander Fleming foi o cientista que descobriu a penicilina [em 1928]. [...]
Em suas pesquisas, Fleming [...] colocava bactérias numa placa cheia de nutrientes, em condições ideais para elas crescerem e se multiplicarem, a fim de poder observá-las. Um dia, o pesquisador saiu de férias e esqueceu, em cima da mesa no laboratório, placas de cultura de uma bactéria [...]. Ao retornar, semanas depois, percebeu que algumas dessas placas estavam contaminadas com mofo, algo bastante comum.
Fleming estava prestes a lavar as placas [...] e então percebeu que, em uma das placas, havia uma área transparente ao redor do mofo, indicando que não havia bactérias naquela região. Aparentemente, o fungo que tinha causado o mofo estava secretando uma substância que matava as bactérias.
Fleming identificou esse fungo como Penicillium notatum e, por isso, chamou a substância produzida por ele de penicilina. Posteriormente, descobriu-se que a penicilina matava também outros tipos de bactérias, e o melhor: ela não era tóxica para o corpo humano, o que significava que poderia ser usada como medicamento. [...]
[...]
[Entretanto,] o uso indiscriminado de antibióticos, tanto por médicos quanto por pacientes, contribuiu, em muito, para o aparecimento de bactérias super-resistentes. Os erros mais comuns que as pessoas cometem são tomar antibióticos para doenças não bacterianas, como a maior parte das infecções de garganta, gripes ou diarreias, e interromper o tratamento antes do prazo recomendado pelo médico.
FONTE: Maria Ramos. É um milagre! Invivo . Fiocruz. Disponível em: http://fdnc.io/bDg. Acesso em: 14 maio 2021. (Título adaptado.)

LEGENDA: Alexander Fleming (1881-1955), médico escocês que descobriu que a ação de um fungo impedia o crescimento de bactérias. FIM DA LEGENDA.

LEGENDA: Cultura do fungo responsável pela produção da penicilina (Penicillium sp.). FIM DA LEGENDA.
Fim do complemento.
80
Vírus
Os vírus são parasitas obrigatórios, ou seja, só sobrevivem no interior de um organismo vivo. Ao entrar nas células de um ser vivo, os vírus utilizam partes dessas células para fazer novas cópias do corpo deles. Nesse processo, acabam destruindo as células e se espalhando pelo corpo do ser vivo infectado para recomeçar o ciclo.
Doenças como a febre amarela e a dengue são causadas por vírus transmitidos por mosquitos. Para se reproduzir, os mosquitos precisam depositar seus ovos na água. Por isso, essas doenças podem ser evitadas com a interrupção do ciclo do mosquito transmissor, por exemplo, não deixando água parada nas moradias e em outros locais.
Gripe e Covid-19 são doenças em que os vírus são transmitidos diretamente de uma pessoa para outra. Para evitar a contaminação por esses vírus, evitar aglomerações, usar máscara e ter hábitos de higiene, como lavar bem as mãos, são atitudes muito importantes.
A raiva é outra doença causada por vírus, mas transmitida por mamíferos por meio de mordidas ou de contato com a saliva contaminada com o vírus. Vacinar cães e gatos previne essa doença. É muito importante manter a carteira de vacinação dos animais de estimação em dia, seguindo as instruções do médico veterinário.
Boxe complementar:
Fique por dentro
Pai, o que é micróbio?
Flávio Alterthum; Telma Alves Monezi. Rio de Janeiro: Atheneu, 2010.
O livro apresenta o mundo dos microrganismos e aborda as relações deles com outros seres vivos.
Fim do complemento.
- Copie o quadro abaixo, pesquise o nome de algumas infecções causadas por vírus, bactérias, fungos e protozoários e complete-o.
Tabela: equivalente textual a seguir.
|
Agente causador |
Infecções |
|---|---|
|
Vírus |
_____. |
|
Bactérias |
_____. |
|
Fungos |
_____. |
|
Protozoários |
_____. |
81
LIGANDO OS PONTOS
Capítulo 9
- Leia o texto em voz alta e responda.
Zoológico de micróbios
Girafa, elefante, zebra, leão são alguns dos animais que normalmente encontramos nos zoológicos. Mas, na Holanda, existe um zoológico diferente, que reúne formas de vida bem menores, invisíveis ao olho nu: os micróbios.
Esse zoológico, chamado de Micropia , expõe mais de cem espécies diferentes de microrganismos […]. Como enxergar essa coleção tão pequena? [...] os visitantes contam com microscópios e imagens aumentadas em telas 3-D, que possibilitam ver os micróbios de todos os ângulos.
Lá, é possível vê-los se movimentar, comer e se reproduzir. Todos os organismos são cultivados em laboratório por microbiologistas do museu. [...]
Mas não precisa ter medo: diferente do que se possa imaginar, a visita ao museu dos micróbios é completamente segura. Os microbiologistas garantem que não há riscos de infecção por seres que sejam nocivos aos seres humanos, já que os visitantes não entram em contato direto com nenhum deles. Além disso, muitos microrganismos são essenciais à nossa vida. Sem eles, não teríamos, por exemplo, o pão, e até mesmo grande parte do oxigênio do planeta.
[...]
FONTE: Zoológico de micróbios. Ciência Hoje das Crianças , 9 dez. 2014. Disponível em: http://fdnc.io/3Ub. Acesso em: 7 jun. 2021.
LEGENDA: Placas com microrganismos que os visitantes observam no zoológico de micróbios (Holanda, 2014). FIM DA LEGENDA.
82
- Quais são os microrganismos encontrados no zoológico de micróbios?
- Como os visitantes do zoológico conseguem ver os microrganismos?
- A visita ao museu é segura, afirmam os microbiologistas. Explique essa afirmação.
- Se não estivessem no museu, como esses seres vivos se relacionariam com o ambiente em que vivem?
- Leia a tirinha e responda.

- Qual é a graça da história?
- Uma medida simples, como lavar as mãos, tem grande importância na diminuição da transmissão de doenças. Por quê?
- Paulinha estava com febre, dores no corpo e mal-estar. A mãe levou-a à médica. Depois de algumas perguntas, a médica diagnosticou uma virose e receitou um medicamento para baixar a
febre
e aliviar a dor. A mãe de Paulinha, no entanto, saiu desconfiada do consultório porque a médica não receitou antibiótico.
- O que você diria à mãe de Paulinha a respeito do medicamento receitado?

83
DESAFIO À VISTA!
Capítulo 10
Neste capítulo, você vai verificar a participação dos microrganismos em diferentes situações do dia a dia.
Quais são os benefícios que os microrganismos podem trazer para o ambiente e para os demais seres vivos?
CAPÍTULO 10. Importância dos microrganismos
- Leia o texto, pesquise o significado das palavras que você não conhece e responda.
Por que comida congelada dura mais tempo?
Porque [a baixa temperatura] impede que os microrganismos no alimento se reproduzam, impedindo o apodrecimento. [...] há mais de 10 mil anos, o [ser humano] só comia alimentos frescos, fossem caçados ou colhidos, pois as tribos eram nômades e não guardavam alimentos. Isso mudou quando se fixaram e começaram a armazenar a comida para os períodos de escassez, percebendo que, no frio, os alimentos duravam mais. [...]
[...]
Quando congelamos o alimento, a baixa temperatura impede a proliferação dos microrganismos, pois eles não conseguem se reproduzir em temperaturas mais baixas. Porém, o processo não mata as bactérias – e sim as torna inativas. Ao descongelar, elas voltarão a se reproduzir. Aliás, quanto maior o calor, mais rápido isso acontece, causando o apodrecimento da comida.
FONTE: Daniela Fescina. Por que comida congelada dura mais tempo? Revista Superinteressante , 14 fev. 2020. Disponível em: http://fdnc.io/fei. Acesso em: 7 jun. 2021.

LEGENDA: Os peixes frescos podem ser congelados para a comercialização e o armazenamento. Após descongelados, devem ser consumidos rapidamente para que não estraguem. FIM DA LEGENDA.
- Que fator ambiental mencionado no texto dificulta o desenvolvimento de microrganismos nos alimentos?
- Em algumas embalagens de leite longa vida, encontramos os dizeres: “Depois de aberto, manter em geladeira”. Por quê?

- A proliferação de microrganismos faz parte da produção de alguns alimentos. Você conhece alimentos feitos por meio da ação de microrganismos?
- Converse com os colegas e façam uma lista desses alimentos.
84
Existem fungos e bactérias que são utilizados na produção de alimentos. É o caso dos fermentos biológicos, compostos de leveduras (um tipo de fungo) e usados na fabricação de pães e bebidas.
No processo de fabricação de pães, o fungo utiliza o amido, substância presente na farinha, como alimento. Nesse processo, ocorre a liberação de gás carbônico no interior da massa do pão, o que a deixa mais porosa e macia.
Bactérias e fungos são utilizados também na produção de queijos. Ao serem colocados no leite, retiram dele alguns nutrientes e liberam substâncias que dão cor, cheiro e textura ao queijo. Dependendo do tempo de fabricação, da técnica e do tipo de microrganismo utilizado, podem ser produzidos diferentes tipos de queijo.

LEGENDA: As leveduras são responsáveis pelo crescimento da massa dos pães. FIM DA LEGENDA.

LEGENDA: Diferentes tipos de queijo podem ser produzidos com a participação de microrganismos. FIM DA LEGENDA.
- Pesquise,
recorte
e cole imagens de alimentos, além dos citados nesta página, que contam com a ação de microrganismos para sua produção.
- Escreva uma legenda para cada uma das imagens pesquisadas.
Boxe complementar:
Fique por dentro
O show da Luna!: doce pão doce
Disponível em: http://fdnc.io/fej. Acesso em: 7 jun. 2021.
Nesse episódio, Luna vai à padaria para comer um pão doce e aprende como a massa, mole e pequena, cresce e vira um pão grande e fofinho com a ação do fermento biológico.
Fim do complemento.
85
Biocombustíveis
Os microrganismos também são utilizados na fabricação dos biocombustíveis.
Os biocombustíveis são um tipo de combustível de origem biológica produzido a partir de vegetais, como cana-de-açúcar, milho, mandioca, beterraba, entre outros.
O etanol e o biodiesel são exemplos de biocombustíveis utilizados atualmente.
O etanol usado como combustível para carros depende de microrganismos para ser produzido. Determinados fungos também podem participar da produção do etanol, que envolve várias etapas. Veja no esquema abaixo como é esse processo.

LEGENDA: Representação esquemática das etapas da produção do etanol de cana-de-açúcar. (Imagem sem escala; cores fantasia.) FIM DA LEGENDA.
Fonte: BIANCHIN, V.; SILVEIRA, G. Como é produzido o etanol? Revista Superinteressante, 4 jul. 2018. Disponível em: http://fdnc.io/7Pk. Acesso em: 7 jun. 2021.
- Explique em que etapa do esquema os microrganismos contribuem com a produção do etanol.
- Por que na etapa 4 é preciso eliminar todos os microrganismos do melado?
86
Analisando rótulos de alimentos
Você já reparou que as embalagens de alimentos apresentam algumas informações impressas? Observe a imagem.

LEGENDA: É possível obter muitas informações sobre um alimento lendo o rótulo dele. (Imagem sem escala; cores fantasia.) FIM DA LEGENDA.
Para determinar essas informações, os pesquisadores observam a quantidade de microrganismos que vão se desenvolvendo no alimento depois de um tempo. Também são analisadas modificações em outros itens, como cor, sabor e cheiro.
O prazo de validade, por exemplo, considera a quantidade de microrganismos que se desenvolvem no alimento depois de um tempo e que, em determinada quantidade, passam a fazer mal à saúde.
Se o prazo de validade estiver vencido ou se percebemos que o alimento está estragado, devemos descartá-lo.
Mas é possível reaproveitar algo? Sim! As embalagens podem ser separadas para a reciclagem depois de lavadas para retirar os restos de alimento de seu interior, e alguns alimentos podem ser utilizados para a produção de adubo, por meio de uma técnica chamada compostagem.
87
Os alimentos mais recomendados para compostagem são: restos de legumes, verduras e frutas, cascas de ovos e pó de café. Por meio dessa técnica, fungos e bactérias alimentam-se dos restos vegetais e promovem sua decomposição. Assim, a quantidade de lixo gerado diminui e o adubo produzido pode ser usado em jardins e hortas.

LEGENDA: Restos vegetais deixam de ir para o lixo quando são destinados à compostagem. FIM DA LEGENDA.
- Observe os rótulos das embalagens de dois alimentos e responda.

LEGENDA: Embalagem do alimento 1. FIM DA LEGENDA.

LEGENDA: Embalagem do alimento 2. FIM DA LEGENDA.
- Qual dos alimentos deve ser guardado na geladeira? Por quê?
- Mesmo alimentos mantidos na geladeira, como o iogurte, não devem ser consumidos após a data de validade. Por quê?
- Todos os resíduos descartados no lixo sofrem a ação dos decompositores? Explique.
88
LIGANDO OS PONTOS
Capítulo 10
- Leia o texto em voz alta e responda.
Cientistas desenvolvem enzima que degrada plástico
Metade da produção anual brasileira de PET [politereftalato de etileno, um tipo de plástico], estimada em 550 mil toneladas, não é reciclada e tem como destino os aterros, lixões e rios, gerando um sério problema ambiental para o país. No mundo, o quadro é ainda mais grave: cerca de oito milhões de toneladas de recipientes plásticos são lançadas todos os anos nos oceanos. Descoberta recente de um grupo internacional de cientistas, com participação de especialistas da Unicamp, pode contribuir para minimizar esse tipo de poluição. Os pesquisadores desenvolveram uma enzima , denominada PETase, que degrada com eficiência o PET. […]
[…] o trabalho teve início após a descoberta, por uma equipe japonesa, em 2016, de uma bactéria encontrada na natureza batizada de Ideonella sakaiensis .
Ao analisar o organismo, os japoneses constataram que ele utilizava o PET como fonte de energia. Numa linguagem mais popular, a bactéria “devorava” o plástico em poucos dias, processo que a natureza levaria dezenas de anos para fazer. Os cientistas verificaram também que a responsável pelo processo de degradação do polímero era a [enzima] PETase. [...]
FONTE: Manuel Alves Filho. Cientistas desenvolvem enzima que degrada plástico. Jornal da Unicamp , 23 abr. 2018. Disponível em: http://fdnc.io/fep. Acesso em: 7 jun. 2021.
Glossário:
Enzima : proteína que acelera reações químicas.
Polímero : material que constitui o plástico.
Fim do glossário.

LEGENDA: O plástico das garrafas PET é um material leve que acaba sendo carregado pelo vento e polui rios e oceanos (Quênia, 2020). FIM DA LEGENDA.
89
- Qual descoberta dos pesquisadores é relatada no texto?
- Qual é a importância dessa descoberta?
- Como as pessoas podem contribuir para dar um destino adequado ao PET?
- Em relação ao aparecimento de doenças, qual é o risco do acúmulo de recipientes, como as garrafas feitas de PET, no ambiente?
- Observe as imagens e responda.


- O que há de diferente com esses alimentos? Descreva o que você observou.
- Por que esses alimentos não devem ser ingeridos?
- A imagem a seguir mostra um profissional preparando placas com meio de cultura para estudo de microrganismos.

- De acordo com o que foi estudado, quais são os benefícios da ação dos microrganismos para o ambiente e os demais seres vivos?
90
DESAFIO À VISTA!
Capítulo 11
Neste capítulo, você vai propor atitudes adequadas para a prevenção de doenças.
Como nosso corpo se defende dos microrganismos que afetam a saúde?
CAPÍTULO 11. Defesas do corpo
- Leia o texto, pesquise o significado das palavras desconhecidas e responda.
Alergia: coça, coça, espirra, empola…
Só de entrar numa sala com mofo Juliana espirra. Pedro fica com a pele empolada quando come camarão. Carlos volta e meia tem asma. O que eles têm em comum?
Tem hora que o corpo da gente vira um campo de batalha. É só aparecer algo estranho por perto que um exército de defesa se arma e vai tentar expulsar o intruso. É esse sistema de defesa do organismo [...] que impede que fiquemos doentes cada vez que entramos em contato com [microrganismos] causadores de infecções.
Uma das formas de o sistema de defesa agir é produzir anticorpos, substâncias que ficam circulando no sangue e que se grudam no intruso, facilitando sua destruição. Os anticorpos só agem contra o microrganismo que induziu sua produção. Mas nosso corpo não distingue o que é um [microrganismo] ou outra coisa diferente, produzindo anticorpos contra qualquer intruso que aparece. [...]
FONTE: Alergia: coça, coça, espirra, empola… Ciência Hoje das Crianças , 9 abr. 1998. Disponível em: http://fdnc.io/fer. Acesso em: 7 jun. 2021.
- Você tem alguma alergia ou conhece alguém que tenha? Que tipo de alergia?
- De acordo com o texto, o que são alergias e por que elas acontecem?

91
Sistema imunitário
O sistema imunitário é o conjunto de estruturas do corpo que defende o organismo de agentes estranhos, como bactérias e vírus causadores de doenças. Essa defesa é feita pela ação de células conhecidas como glóbulos brancos. Entre as suas funções, está a produção de substâncias chamadas de anticorpos, que vão atuar especificamente contra o agente estranho ao corpo.
Veja a seguir alguns exemplos de como o sistema imunitário funciona.
Quando alguém se corta, pode haver infecção por bactérias, vírus e outros agentes que penetram no corpo através do ferimento.
Então, os glóbulos brancos do sangue agem para identificar e eliminar os invasores, destruindo-os e produzindo anticorpos contra eles. Na região do ferimento, pode haver formação de pus, que é uma mistura de líquidos, glóbulos brancos e bactérias. Lavar bem o ferimento com água e sabão ajuda a prevenir essas infecções.
Outra forma de ação do sistema imunitário ocorre quando contraímos os vírus da gripe. Esses vírus penetram no organismo pelo nariz ou pela boca. Nessa situação, o sistema imunitário aciona os glóbulos brancos, que produzem anticorpos para se defender dos vírus. Durante esse processo, pode ocorrer febre, que é outra reação do sistema imunitário à doença.
Em geral, o sistema imunitário é capaz de proteger nosso corpo de doenças causadas por agentes invasores. Em outras situações, no entanto, essa defesa não é suficiente e a doença persiste. Nesses casos, são necessários tratamentos médicos, como medicamentos ou cirurgias, para que a pessoa se recupere.

LEGENDA: Representação esquemática da reação do sistema imunitário a um corte na pele. (Imagem sem escala; cores fantasia.) FIM DA LEGENDA.
Fonte: ABBAS, A. K. et al. Imunologia celular e molecular. 9ª ed. Rio de Janeiro: Guanabara Koogan, 2019.

- Convidem um profissional da área da saúde para conversar com a turma sobre algumas doenças comuns na infância. Entre outras questões, perguntem como essas doenças são contraídas e como podem ser evitadas.
- Faça uma lista com o nome das doenças mais comuns na infância.
- Depois da conversa com o profissional convidado, escreva um texto com as principais características das doenças que foram abordadas.
92
Vacinas
As vacinas ajudam o corpo a produzir anticorpos contra agentes infecciosos específicos, para os quais elas foram produzidas, prevenindo determinadas doenças. Se a pessoa vacinada entrar em contato com o agente causador da doença, o sistema imunitário conseguirá combatê-lo rapidamente.
As vacinas são seguras porque passam por testes rigorosos para serem aprovadas. É muito raro acontecer uma reação que prejudique o organismo e, quando ocorre algo, geralmente costuma ser uma febre baixa ou dor no local da injeção.

LEGENDA: Criança recebendo vacina (Campo Novo dos Parecis, MT, 2018). FIM DA LEGENDA.
- Peça a seus responsáveis uma cópia da parte interna de sua caderneta de vacinação, na qual estão indicadas as vacinas que você já tomou. Observe a tabela abaixo e responda.
Tabela: equivalente textual a seguir.
|
Calendário nacional de vacinação infantil |
||
|---|---|---|
|
Idade |
Vacina |
Dose |
|
Ao nascer |
BCG |
Uma dose |
|
Hepatite B |
||
|
2 meses |
Pentavalente |
1ª dose |
|
Vacina inativada poliomielite |
||
|
Rotavírus |
||
|
Pneumocócica 10 |
||
|
3 meses |
Meningocócica C |
1ª dose |
|
4 meses |
Pentavalente |
2ª dose |
|
Vacina inativada poliomielite |
||
|
Rotavírus |
||
|
Pneumocócica 10 |
||
|
5 meses |
Meningocócica C |
2ª dose |
|
6 meses |
Pentavalente |
3ª dose |
|
Vacina inativada poliomielite |
||
|
9 meses |
Febre amarela |
1ª dose |
|
12 meses |
Tríplice viral (sarampo, caxumba e rubéola) |
1ª dose |
|
Pneumocócica 10 |
Reforço |
|
|
Meningocócica C |
||
|
15 meses |
DTP (difteria, tétano e coqueluche) |
1º reforço |
|
Vacina oral poliomielite |
||
|
Hepatite A |
Uma dose |
|
|
Tetraviral (sarampo, caxumba, rubéola e varicela) |
||
|
4 anos |
DTP (difteria, tétano e coqueluche) |
2ᵒ reforço |
|
Vacina oral poliomielite |
||
|
Varicela atenuada |
Uma dose |
|
|
Febre amarela |
Reforço |
|
|
9 a 14 anos (meninas) 11 a 14 anos (meninos) |
HPV |
Duas doses com seis meses de intervalo |
Fonte: BRASIL. Ministério da Saúde. Calendário Nacional de Vacinação. Disponível em: http://fdnc.io/fes. Acesso em: 4 jun. 2021.
- Você já tomou todas as vacinas do calendário nacional de vacinação? Ainda falta alguma?
- Pesquise uma doença que já tenha sido erradicada no Brasil graças às campanhas de vacinação.
- Não são apenas as crianças que tomam vacinas. Existem algumas vacinas que podem ser tomadas por adolescentes, adultos e idosos. Pesquise quais são essas vacinas.
93
Soros
Em algumas situações específicas, o corpo precisa reagir rapidamente à invasão de um elemento estranho. Nesses casos, o sistema imunitário precisa de auxílio externo para ter uma resposta adequada e rápida. É o que acontece, por exemplo, quando uma pessoa é picada por serpente, aranha ou escorpião e precisa receber o soro que contém anticorpos prontos.
Também existem soros para o tratamento do tétano, do botulismo, da raiva, entre outras doenças. Nessas situações, os pacientes recebem um soro que contém os anticorpos que vão combater o elemento estranho que invadiu o corpo.
Veja como é preparado um soro para combater elementos existentes no veneno de serpentes. A mesma técnica pode ser usada para se obter soro para o veneno de aranhas e de escorpiões.

LEGENDA: Representação esquemática das etapas de preparação de soro contra veneno de serpentes. (Imagem sem escala; cores fantasia.) FIM DA LEGENDA.
Fonte: MONACO, L. M. (org.). Soros e vacinas do Butantan. 1ª ed. São Paulo: Instituto Butantan, 2018. Disponível em: http://fdnc.io/fev. Acesso em: 4 jun. 2021.
94
- Leia o texto, pesquise o significado das palavras desconhecidas e responda.
A Revolta da Vacina
A imagem abaixo retrata a Revolta da Vacina, ocorrida no Rio de Janeiro em 1904. Nesse período, o médico Oswaldo Cruz foi nomeado diretor-geral da Saúde Pública, com a missão de acabar com doenças como febre amarela, peste bubônica e varíola. A obrigatoriedade da vacinação, imposta de forma autoritária, somada a outros descontentamentos do povo, acabou levando as pessoas a se revoltarem.
Mesmo contra a vontade, a população foi vacinada e, em 1907, a febre amarela foi erradicada e os esforços de Oswaldo Cruz foram reconhecidos.
Para se ter uma ideia da importância das campanhas de vacinação, a varíola foi considerada erradicada em 1980. Com as campanhas, várias pessoas são vacinadas ao mesmo tempo, menos pessoas ficam doentes e a transmissão dos microrganismos causadores de doenças é reduzida. Dessa forma, diminuem ou são eliminados os riscos de epidemia para a população. Se poucas pessoas são vacinadas, a maior parte da população fica sem proteção e pode acabar adoecendo.
Fonte: BRASIL. Ministério da Saúde. Centro Cultural da Saúde. A revolta da vacina. Revista da Vacina . Disponível em: http://fdnc.io/5ut. Acesso em: 4 jun. 2021. (Texto adaptado.)

LEGENDA: “Guerra Vaccino-Obricateza !”, charge de Leônidas, publicada em 29 de outubro de 1904 na revista O Malho. FIM DA LEGENDA.
- Qual é a importância das campanhas de vacinação?
- Imagine que você é um ajudante de Oswaldo Cruz, em 1904. Elabore uma frase para ajudar na campanha obrigatória de vacinação e evitar que as pessoas fiquem assustadas. Utilize argumentos estudados nesta unidade.
Boxe complementar:
Fique por dentro
Vacina é tudo de bom
Bianca Encarnação. Brasília: Instituto Alfa e Beto, 2018.
O livro conta a história das vacinas no mundo e apresenta a importância da prevenção das doenças.
Fim do complemento.
95
LIGANDO OS PONTOS
Capítulo 11
- Luísa foi almoçar com os pais e pediu o prato do dia, sem saber que o molho especial era feito com camarão, ao qual ela é alérgica.
- O que acontecerá com Luísa se ela ingerir essa refeição? Por quê?
- Que estratégias o corpo apresenta para se proteger contra agentes estranhos, como vírus e bactérias?

- Leia a tirinha e responda.

- Como as vacinas ajudam o corpo a combater as doenças?
- Quais podem ser os agentes causadores de doenças que deixaram a personagem da tirinha doente?
- Qual é o tipo de medicamento que um médico poderia indicar para o menino se a causa da doença fosse uma bactéria?
96
- Observe a imagem e responda.
- Quais são os sintomas da gripe?
- Como o corpo pode ficar imune à gripe?

- Leia a manchete e responda.
Página da internet.
Vacinação de crianças no país atinge índice mais baixo em 16 anos
Meta é imunizar 95% [dos bebês e crianças], mas cobertura variou entre 71% e 84% contra sarampo.
FONTE: Natália Cancian. Vacinação de crianças no país atinge índice mais baixo em 16 anos. Folha de S.Paulo , 19 jun. 2018. Disponível em: http://fdnc.io/fez. Acesso em: 7 jun. 2021.

Fim da página.
- Interprete as informações da manchete e tente descobrir o significado da palavra imunizar.
- Qual é o problema apontado pela manchete? O que esse problema pode causar às crianças?
- Qual é o agente causador do sarampo? Com que idade a criança deve tomar essa vacina?
- Em sua opinião, os riscos da não vacinação são somente individuais ou podem afetar mais pessoas? Explique sua resposta.
97
DESAFIO À VISTA!
Capítulo 12
Neste capítulo, você vai propor atitudes e medidas adequadas para a prevenção de doenças.
Qual é a relação entre a higiene pessoal e a do ambiente e a saúde?
CAPÍTULO 12. Higiene e saúde
Manter o corpo limpo é uma das formas de evitar muitas doenças. Vamos pensar sobre isso?
Observação: Você já estudou, no 1º ano, a importância dos hábitos de higiene. Relembre-os e converse com os seus colegas. Fim da observação.
- Leia o texto em voz alta e responda.
Como o vírus entra no nosso corpo?
[...]
Os vírus são seres muito pequenos, menores ainda que uma bactéria que a gente só vê ao microscópio. Mas como um vírus entra na gente?
Nosso corpo tem barreiras que tentam impedir sua entrada. A pele é uma delas e é uma barreira natural que o vírus consegue ultrapassar quando temos uma ferida, por menor que ela seja. O vírus pode entrar, também, através dos olhos, da boca e do nariz.
Uma vez dentro do nosso corpo, o vírus precisa entrar na célula para que ele possa se multiplicar e sobreviver. Pra isso, ele se encaixa na superfície de uma célula como uma chave se encaixa na fechadura, o que facilita sua entrada.
Existem vários tipos de vírus, sendo que cada um deles tem um tipo preferido de célula. Por isso, os vírus são capazes de causar doenças diferentes como o sarampo, a gripe, a caxumba, a dengue e a Aids. […]
FONTE: Como o vírus entra no nosso corpo? Universidade das Crianças UFMG . Disponível em: http://fdnc.io/feA. Acesso em: 7 jun. 2021.

LEGENDA: Representação do vírus do sarampo. (Imagem sem escala; cores fantasia.) FIM DA LEGENDA.
- Como um vírus entra no organismo humano?
- Como o nosso corpo reage à entrada do vírus?
98
Boxe complementar:
Quero saber!
O que faz os ferimentos pararem de sangrar?
Para responder a essa pergunta, é preciso entender a composição do sangue.
A maior parte das células encontradas no sangue são os glóbulos vermelhos. Sua principal função é o transporte de gases (oxigênio e gás carbônico).
Como estudado anteriormente, os glóbulos brancos são células que têm a função de defender o organismo de corpos estranhos.
Quando ocorre um ferimento em um vaso sanguíneo, as plaquetas, que são elementos do sangue, aglomeram-se no local. Com os glóbulos vermelhos e as proteínas, elas interrompem o sangramento e auxiliam na cicatrização do ferimento.
É assim que os ferimentos param de sangrar. Quando eles são maiores, essa interrupção é um pouco mais lenta e, às vezes, é necessária uma sutura, ou seja, alguns pontos que fecham o corte e auxiliam a ação das plaquetas.
Lembre-se de que o uso de equipamentos de segurança durante a prática de atividades físicas pode ajudar a evitar ferimentos. Se, mesmo assim, você se machucar, é importante lavar o ferimento com água e sabão para impedir infecções. Nos casos mais graves, é necessário procurar ajuda médica.


LEGENDA: Representação esquemática dos elementos que compõem o sangue. (Imagem sem escala; cores fantasia.) FIM DA LEGENDA.

LEGENDA: Representação esquemática do processo de interrupção do sangramento de um ferimento. (Imagem sem escala; cores fantasia.) FIM DA LEGENDA.
Fonte das imagens: ABBAS, A. K. et al. Imunologia celular e molecular. 9ª ed. Rio de Janeiro: Guanabara Koogan, 2019.
Fim do complemento.
99
Saneamento básico e saúde
A prevenção de doenças causadas por microrganismos depende de medidas individuais, como higiene pessoal, e de cuidados coletivos. Parte desses cuidados estão relacionados ao saneamento básico.
- Observe as imagens e responda.

LEGENDA: Rio poluído por lançamento de esgoto doméstico (Vila Velha, ES, 2019). FIM DA LEGENDA.

LEGENDA: Córrego poluído com lixo e esgoto doméstico (São Paulo, SP, 2019). FIM DA LEGENDA.

LEGENDA: Água acumulada em pneu abandonado (Nova Iguaçu, RJ, 2020). FIM DA LEGENDA.
- Que riscos podem ser identificados nessas imagens em relação à transmissão de doenças causadas por vírus, bactérias e protozoários? Retome a pesquisa da página 80 sobre as doenças para responder a essa questão.
100
3. Leia a notícia e responda.
Página da internet.
Saneamento básico e qualidade de vida
[…]
“A qualidade de vida da população está diretamente relacionada com o saneamento”, afirma Deise Paludo, [...] da Universidade Federal da Fronteira Sul (UFFS) [...]. Ela destaca que o impacto ambiental da falta da coleta e tratamento de esgoto sanitário, a coleta e o transporte adequado dos esgotos urbanos são tão importantes quanto os serviços de coleta e destinação de resíduos sólidos. “Os principais impactos do lançamento de esgotos sem tratamento estão relacionados à poluição dos recursos hídricos por matéria orgânica, que irá provocar [...] o crescimento exagerado de algas [...]; além disso, a disposição de esgotos não tratados é responsável pela contaminação de solos e cursos d’água por organismos patogênicos (bactérias, fungos e vírus), causadores de diversas doenças”, argumenta Deise [...].
FONTE: Observatório Social discute saneamento básico para o futuro de Erechim. Bom Dia , 18 fev. 2019. Disponível em: http://fdnc.io/feB. Acesso em: 4 jun. 2021. (Título adaptado.)

Fim da página.
- A notícia relata a importância do saneamento básico. Pesquise notícias sobre saneamento básico relacionadas ao lugar onde você vive.
- Quais são as manchetes das notícias?
- Quais são os principais problemas identificados nas notícias pesquisadas?
- Como esses problemas podem afetar as pessoas que moram nesses locais?

- Converse com os colegas e o professor sobre o que vocês acham que pode ser feito para resolver os problemas identificados. Escreva em seu caderno algumas ideias que vocês discutiram.
101
O saneamento básico é um conjunto de cuidados com a água, o esgoto e o lixo de determinado local.
As principais atividades desse setor estão ligadas à coleta e ao tratamento dos resíduos produzidos pelas pessoas, como o esgoto e o lixo.
Serviços como esses contribuem para a prevenção da poluição do ambiente e garantem o fornecimento de água de boa qualidade às pessoas.
- Na imagem, o que está indicando a placa colocada na praia? O que pode ter causado essa situação?

LEGENDA: Praia de São Marcos (São Luís, MA, 2019). FIM DA LEGENDA.
Os profissionais que trabalham com saneamento básico são treinados para localizar e combater os organismos transmissores de doenças, como os mosquitos da dengue e da malária. Medidas como essas são necessárias para o controle da reprodução desses organismos, impedindo seu contato com a população e a disseminação das doenças.

LEGENDA: Agente sanitarista buscando eliminar focos de reprodução do mosquito Aedes aegypti (Itaparica, BA, 2019). FIM DA LEGENDA.

LEGENDA: Técnicos sanitaristas coletando água do Rio Paraopeba para análise em laboratório (Brumadinho, MG, 2019). FIM DA LEGENDA.
102
LIGANDO OS PONTOS
Capítulo 12
- Observe a imagem e responda.
- O que a pessoa está fazendo?
- Que riscos para a saúde essa atitude pode trazer?

LEGENDA: Rua alagada pelas chuvas (São Paulo, SP, 2019). FIM DA LEGENDA.
- A ingestão de água ou de alimentos contaminados pode ocasionar a disenteria bacteriana.
- Explique como o saneamento básico pode diminuir o número de casos de disenteria.
- Por que a disenteria pode provocar a morte por desidratação se não for tratada? Pesquise, se for necessário.
- Observe o quadro e responda.
Tabela: equivalente textual a seguir.
|
Nome da doença |
Agente transmissor |
Sintomas |
Como ocorre a transmissão |
|---|---|---|---|
|
Gripe |
Vírus |
Dores no corpo, tosse, febre, entre outros. |
Pela saliva contaminada transmitida por meio de espirro, tosse, beijo e compartilhamento de copos e talheres. |
|
Cólera |
Bactéria |
Diarreia, vômitos, dores de barriga e febre alta. |
Pela ingestão de água, frutas ou verduras contaminadas pela bactéria. |
|
Amebíase |
Protozoário |
Diarreia, dores na barriga e febre. |
Pela ingestão de água e alimentos contaminados e por falta de cuidados de higiene (como não lavar as mãos após usar o banheiro). |
- Qual é a doença descrita no quadro que pode ter sua transmissão evitada por meio do uso de uma máscara cobrindo o nariz e a boca?
- Quais são as doenças descritas no quadro que podem ser evitadas por meio da higienização dos alimentos?
- Por que o simples ato de lavar as mãos pode evitar muitas doenças?
103
Ciências em contexto
Leia o texto em voz alta e responda.
Fossa séptica biodigestora
A fossa séptica biodigestora é uma solução tecnológica que trata o esgoto do vaso sanitário, produzindo um efluente rico em nutrientes que pode ser utilizado no solo como fertilizante. Com o sistema de fossa séptica biodigestora desenvolvido pela Embrapa Instrumentação, o dejeto humano (fezes e urina), canalizado diretamente do vaso sanitário, é tratado e transformado em adubo orgânico pelo processo de biodigestão. [...]
De fácil instalação e baixo custo, [...] o sistema básico, dimensionado para uma casa com até cinco moradores, é composto por três caixas interligadas, e a única manutenção é adicionar todo mês uma mistura de água e esterco bovino fresco (5 litros de cada). O esterco bovino fresco fornece as bactérias que estimulam a biodigestão dos dejetos, transformando o esgoto em adubo.
Como funciona?
A primeira caixa deve ser preenchida com 20 L de uma mistura de 50% de água e 50% de esterco bovino (fresco) para aumentar a atividade microbiana – biodigestão das fezes.
O processo deverá ser repetido a cada 30 dias com 10 L da mistura de água e esterco bovino por meio de uma válvula de retenção.
- Na primeira caixa, morrem cerca de 70% das bactérias.
- Na segunda caixa, morre o restante.
- Na terceira caixa, o líquido está sem bactérias e outros microrganismos e pode ser utilizado como adubo na preparação da terra.
FONTE: Wilson Tadeu Lopes da Silva. ABC da agricultura familiar : saneamento básico rural. Brasília: Embrapa, 2014. Disponível em: http://fdnc.io/feE. Acesso em: 4 jun. 2021. (Texto adaptado.)

LEGENDA: Representação esquemática da fossa séptica biodigestora. (Imagem sem escala; cores fantasia.) FIM DA LEGENDA.
104
- Explique por que a fossa séptica biodigestora é uma boa solução para locais sem saneamento básico.
- Como o esgoto do vaso sanitário é tratado na fossa séptica biodigestora?
3. Qual é o papel das bactérias contidas no esterco bovino no tratamento do esgoto na fossa séptica biodigestora?
VAMOS RETOMAR
- Observe a imagem e responda.

LEGENDA: Cartaz do Ministério da Saúde que fez parte da campanha de vacinação contra a gripe em 2020. FIM DA LEGENDA.
- Qual é a diferença entre soro e vacina?
- Que argumentos você utilizaria para informar a importância das campanhas de vacinação como a que aparece na imagem?
- Os microrganismos estudados são benéficos ou trazem danos aos seres humanos? Justifique sua resposta.
6. Qual é a importância dos microrganismos para o ambiente?
105
Mão na massa
Importância das vacinas para a saúde
As campanhas de vacinação acontecem no Brasil há bastante tempo. Veja os cartazes de algumas delas.

LEGENDA: Cartaz da campanha nacional de vacinação contra o sarampo em 2020. FIM DA LEGENDA.

LEGENDA: Cartaz da campanha de atualização da caderneta da vacinação em 2020. FIM DA LEGENDA.
Agora é a sua vez! Como podemos compartilhar com a comunidade escolar a importância das vacinas para a saúde?

Organizem-se em grupos para a realização da atividade.
- Entrevistem um profissional da saúde ou pesquisem na internet informações para escrever alguns argumentos que defendam a importância das vacinas. Anote os argumentos que você e seu grupo elaboraram.
Com base nesses argumentos, vocês podem elaborar cartazes para ser expostos na escola, vídeos ou áudios para ser compartilhados digitalmente ou escolher outras sugestões.
Antes de executar a proposta do grupo, criem um rascunho com as ideias centrais.
Agora é só compartilhar com a comunidade escolar!